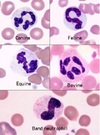

Define inflammation
The reaction of vascularized living tissues to local injury whereby there are a series of changes in the terminal vascular bed, in blood, and in CT to eliminate the offending irritant and repair damaged tissue.
What are the 3 general participants in the inflammatory process?
- Cellular/tissue participants
- Humoral participants
- Chemical participants (cytokines)
What are the 3 functions of inflammation?
- Protecting the body
- Containing and isolating injurious agents
- Achieving healing and repair
It is very common to have some degree of ____ in areas of inflammation and vice versa.
Necrosis
Necrosis that is not initially the result of inflammation will invariably incite a _____________
Secondary inflammation response
What are the 5 cardinal signs of inflammation?
- Pain
- Heat
- Swelling
- Redness
- Loss of function.
Inflammation is a process involving _____ participants.
Multiple
Inflammation occurs only in ____ tissue.
Living: need blood.
Inflammation involves a series of events which overlap and form a ______.
Continuum
Inflammation is a response to an ______ event.
Initiating
How can inflammation be harmful?
- Can lead to necrosis
- Chronic cases can predispose to neoplasia (IBD -> lymphoma)
Inflammation is primarily a _____ reaction.
Defensive
The early stages of inflammation are relatively ____ across the board regardless of the _____.
stereotypical across the board regardless of the nature of the irritant.
Many components of inflammation are found in the ____.
Blood stream
What does it mean that inflammation is a ‘surface phenomenon’?
Cell membrane changes or signals are important.
What is the overall goal of acute inflammation?
Get cells to the sources: WBC’s migrate from circulation, are activated, and leave the microvasculature through a process involving cytokines, selective adhesion, and migration between endothelial cells.
What are the major cell types seen with acute inflammation?
- Mainly neutrophils: first at the site of injury
- Lymphocytes
- Macrophages in a small amount but they accumulate over time so are more prominent in chronic phase.
In which phase of inflammation does vascular leakage occur?
In the acute phase: leads to fluid build up, heat, and redness (edema belongs to acute phase).
Fibrin and exudate (pus) belong to which phase of inflammation?
Acute: amorphous pink material on histology due to proteins.
What is the overall goal of chronic inflammation?
Repair (this is why there is so much fibrosis happening)
What is the cell type distribution seen with chronic inflammation?
Macrophages, lymphocytes, and plasma cells
neutrophils can still be seen but in a much smaller amount than with acute phase.
The presence of fibroblasts in chronic inflammation leads to what?
Fibrosis: scar formation.
What species is prone to higher levels of granulation tissue production during chronic inflammation?
Horses.
What are the differences seen in an otherwise stereotypical inflammatory reaction?
- Depends on the host and the initiating agent
- Differences seen in nature of exudate, distribution, time course, and severity of the reaction.